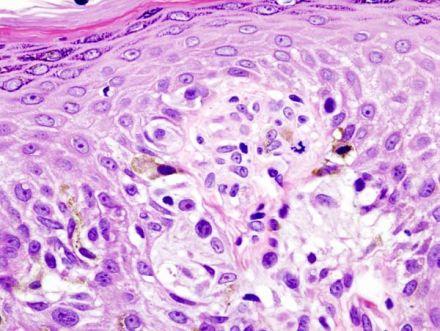

神奇未来小药丸
药可以拯救人类?来看这篇文章是关于未来药丸的一个集合。
1.癌症疫苗
抗癌的药物千万种,现如今,战队们的思路是人体接种癌症疫苗。科学家们目前的成果是,在实验室环境改变了人体免疫细胞,然后再送回人体内。如图的胎记瘤疫苗是第一批的实验对象。现在是很复杂,可能以后治疗过程就如接种水痘般简单。
2.男用避孕药
伟哥的灿烂带来另外的呼声,男用避孕药。研究的方向是,控制精子的生产或者防止射精(ohmygod)。不明朗的未来不仅来自技术的男度,更加是来自男人的欺骗天性,天知道他到底有没有嗑药呢?











